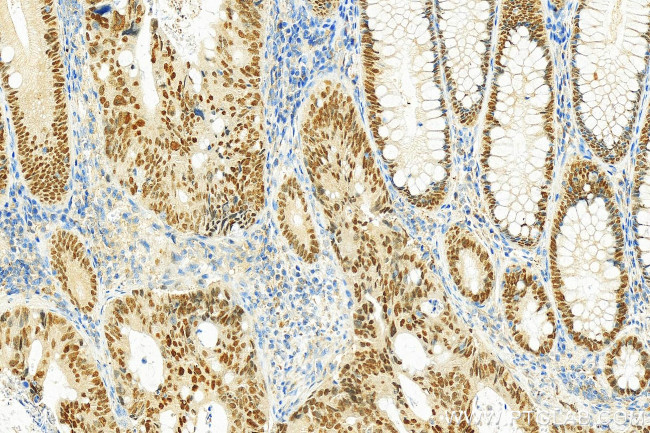
HNF4A Antibody in Immunohistochemistry (Paraffin) (IHC (P))

Search
Proteintech
HNF4A Polyclonal Antibody
{{$productOrderCtrl.translations['antibody.pdp.commerceCard.promotion.promotions']}}
{{$productOrderCtrl.translations['antibody.pdp.commerceCard.promotion.viewpromo']}}
{{$productOrderCtrl.translations['antibody.pdp.commerceCard.promotion.promocode']}}: {{promo.promoCode}} {{promo.promoTitle}} {{promo.promoDescription}}. {{$productOrderCtrl.translations['antibody.pdp.commerceCard.promotion.learnmore']}}
产品信息
26245-1-AP
种属反应
已发表种属
宿主/亚型
分类
类型
抗原
偶联物
形式
浓度
规格
纯化类型
保存液
内含物
保存条件
运输条件
产品详细信息
Immunogen sequence: MRLSKTLVDM DMADYSAALD PAYTTLEFEN VQVLTMGNDT SPSEGTNLNA PNSLGVSALC AICGDRATGK HYGASSCDGC KGFFRRSVRK NHMYSCRFSR QCVVDKDKRN QCRYCRLKKC FRAGMKKEAV QNERDRISTR RSSYEDSSLP SINALLQAEV LSRQITSPVS GINGDIRAKK IASIADVCES MKEQLLVLVE WAKYIPAFCE LPLDDQVALL RAHAGEHLLL GATKRSMVFK DVLLLGNDYI VPRHCPELAE MSRVSIRILD ELVLPFQELQ IDDNEYAYLK AIIFFDPDAK GLSDPGKIKR LRSQVQVSLE DYINDRQYDS RGRFGELLLL LPTLQSITWQ
靶标信息
Hepatocyte nuclear factor 4 alpha (HNF4 alpha) is an orphan nuclear receptor. HNF4a is expressed in the liver, kidney, intestine, and pancreas. Mutation of HNF4a in humans has been associated with maturity-onset diabetes of the young type 1 (MODY1). HNF4 binds to DNA as an exclusive homodimer. The HNF4a gene is alternatively spliced and may generate up to nine different isoforms, HNF4a1 through HNF4a9.
仅用于科研。不用于诊断过程。未经明确授权不得转售。
生物信息学
蛋白别名: FLJ39654; hepatic nuclear factor 4 alpha; Hepatocyte nuclear factor 4-alpha; HNF-4-alpha; HNF4-alpha; HNF4A wild type; HNF4a7; HNF4a8; HNF4a9; HNF4alpha10/11/12; Nuclear receptor subfamily 2 group A member 1; TCF-14; transcription factor; Transcription factor 14; Transcription factor HNF-4
基因别名: FRTS4; HNF4; HNF4A; HNF4a7; HNF4a8; HNF4a9; HNF4alpha; MODY; MODY1; NR2A1; NR2A21; TCF; TCF-14; TCF14
UniProt ID: (Human) P41235
Entrez Gene ID: (Human) 3172